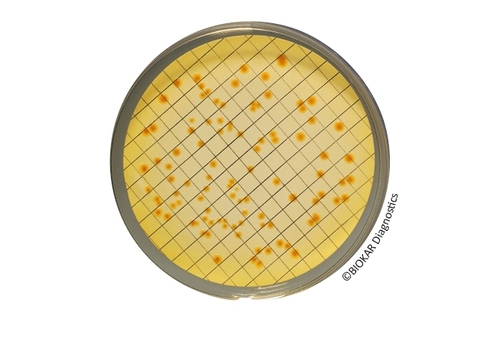

Escherichia coli
The presence of coliform bacilli and E.coli in particular is an indicator of feacel contamination. Whereas the majority of these enterobacteria are quite harmless, some representatives of this group can cause serious health problems.
The test of food, beverages and water for the absence of these microorganisms prior to their release for trade is therefore regulated in quidelines, standards and laws.

Chromogenic Coliform Agar (CCA)
Chromogenic Coliform Agar Chromogenic Coliform Agar (CCA) is used for the detection and..
More
COMPASS® cc Agar
COMPASS® CC Agar COMPASS® cc Agar allows the direct enumeration of Escherichia coli and..
More
COMPASS® Ecc Agar
COMPASS® Ecc Agar COMPASS® Ecc Agar is a selective agar for the simultaneous and specific..
More
EC Broth
EC Broth EC Broth (abbreviation for Escherichia coli) is a selective media used for the..
More
EMB Agar
EMB Agar Levine EMB Agar, originally recommended by Levine, is used to isolate and identify..
More
Glutamate Broth
Glutamate Broth Glutamate broth is used enumeration of β-glucuronidase positive E.coli in food..
More
Laurylsulfate Tryptose Broth
Laurylsulfate Tryptose Broth Laurylsulfate-Tryptose broth is a selective enrichment media used..
More
MacConkey Broth Purple
MacConkey Broth Purple MacConkey Broth Purple complies with the formula described in the..
More
MUG 50 mg Supplement
MUG 50 mg Supplement MUG 50 mg Supplement is used in selective media for the detection and..
More
Peptone Water
Peptone Water Peptone water is used for the culture of microorganisms with no particular growth..
More
Tergitol 7 Agar
Tergitol 7 Agar Tergitol 7 Agar is used for the enumeration of Escherichia coli and coliform..
More